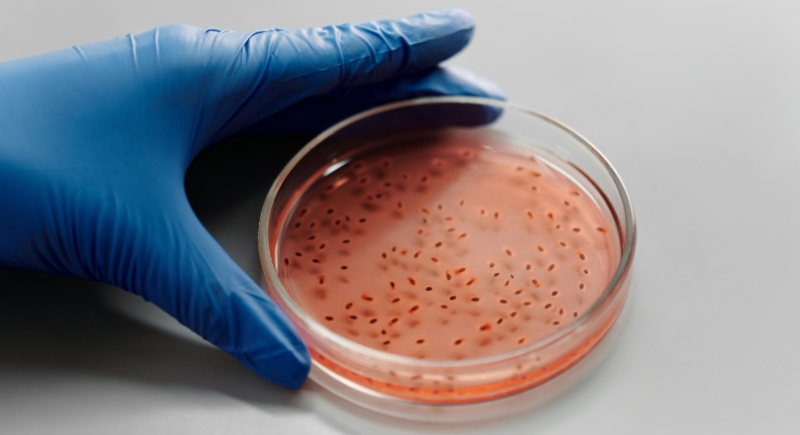

Why One Woman Says Her $25K Cat Clone Was Worth It
Losing Chai left Kelly Anderson with a kind of absence that stayed in the room long after her cat was gone. When she began reading about cloning, it wasn’t out of hope for a perfect copy. It was a way to soften an ending that felt too sudden. The science didn’t promise familiarity, only the possibility of sharing her home with a life connected to the one she had lost, and that was enough for her to consider taking the step.
The Moment That Changed Everything

Credit: Getty Images
What happened at the clinic became the center of Kelly’s decision. Chai had swallowed a piece of plastic while staying with a sitter, and the removal surgery worked. The complication came later, when anesthesia triggered a reaction that the staff couldn’t reverse. Kelly arrived expecting pickup instructions and instead faced a sudden loss that pushed her toward cloning.
A Late-Night Search That Shifted Her Thinking

Credit: pexels
After Chai died, Kelly spent evenings talking things through with her roommate and looking up anything that might help her make sense of the loss. That search led her to Viagen, a cloning company nearby. What reassured her most was learning that a clone wouldn’t be an identical copy of Chai’s personality. Understanding that made the idea feel more grounded and easier for her to consider.
Chai’s Role in All of This

Credit: pexels
Chai had been around since Kelly’s college years and carried a mix of sass and empathy that made rough days easier. Their routines shaped the apartment in subtle ways, and losing that presence felt jarring. Keeping a link to Chai’s genetics became Kelly’s way of holding onto something steady during a chaotic moment.
A Price Tag That Required Commitment

Credit: pexels
The $25,000 cloning fee stood well beyond Kelly’s savings, but she moved forward by taking out a loan. Viagen also warned her that a damaged tissue sample might slow progress, which it did. What she expected to be a short wait stretched into four years, yet she stayed committed to finishing what she started.
Meeting Belle for the First Time

Credit: Getty Images
After years of waiting, Kelly didn’t know what to expect. When Belle arrived, she fell asleep on Kelly’s lap almost immediately, and the moment felt strangely calm rather than emotional. Instead of mirroring Chai, Belle carried her own energy, which helped Kelly see the experience as an addition to her life rather than a substitution.
A Clone With Her Own Playbook

Credit: Canva
Belle grew into a very different cat than people expected. Belle grew into an adventurous cat who enjoys exploring parks, stores, and breweries, outings that she embraced from kittenhood in a way Chai never could. Viagen’s explanation of how the environment shapes personality made more sense as she matured.
The Online Audience That Watched It Happen

Credit: pexels
Kelly had already documented Chai’s life, so followers were invested when she announced her cloning plans. Belle’s arrival turned that interest into steady engagement. The Clone Kitty account grew quickly as people asked about ethics, behavior differences, and the science behind the process.
Feedback That Isn’t Always Friendly

Credit: Getty Images
Not everyone reacted warmly, though. Kelly receives criticism almost daily, and once opened a pointed message from PETA urging her to speak out against cloning. She responded by mentioning her volunteer work and the more than 100 foster cats she has cared for. To her, the choice came from grief, not an attempt to spark controversy.
Science Behind a Modern Repeat
Credit: pexels
The cloning method used for Belle mirrors the somatic cell nuclear transfer technique that created Dolly the sheep. A donor egg receives DNA from the original pet, and the resulting embryo goes to a surrogate. Reporting on cloning has cited a 2022 study indicating that successful outcomes remain low, at about 2 percent.
Advice for Anyone Curious

Credit: pexels
Kelly tells people to treat cloning as a thoughtful, slow decision rather than a reaction to heartbreak. She emphasizes that personality cannot be duplicated and that tissue samples matter far more than most realize. Many vets can store them during routine procedures, such as dental cleanings. She even saved one from her dog Ghost, though repeating the process isn’t in her budget.